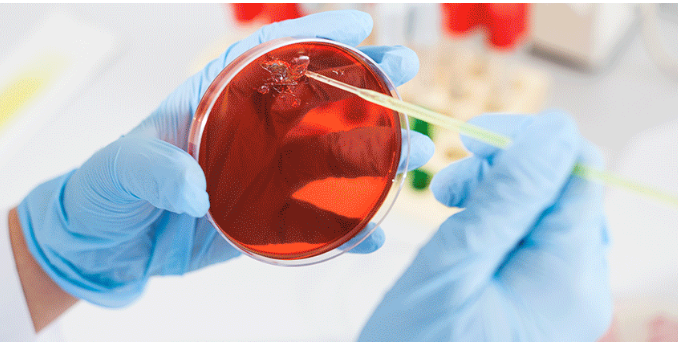

Analityk w Akredytowanym Laboratorium Badawczym (tester smaku)
Jesteśmy największą w Polsce firmą świadczącą niezależne usługi w zakresie badań i ekspertyz jakościowych, dysponującą siecią akredytowanych laboratoriów analitycznych.
Dla naszych klientów z wielu branż oferujemy szeroki wachlarz wyspecjalizowanych analiz żywności, kosmetyków i produktów chemii gospodarczej, farmaceutyków, opakowań i artykułów przemysłowych, paliw ciekłych i stałych i wielu innych.
J.S. HAMILTON POLAND Sp. z o.o. posiada ponad 10 oddziałów w Polsce oraz na rynku zagranicznym. Łącznie zatrudnia ponad 1000 osób.
Analityk w Akredytowanym Laboratorium Badawczym (tester smaku)Opis stanowiska:
Jeśli lubisz próbować różnorodne produkty spożywcze, testować, kosztować i poznawać nowe smaki, a dodatkowo czujesz, że świetnie sprawdziłbyś się/sprawdziłabyś się w roli osoby oceniającej dany produkt. Posiadasz doświadczenie gastronomiczne lub może wykształcenie kierunkowe: gastronomia, towaroznastwo, technologia żywności i chcesz zacząć swoją karierę w największym Akredytowanym Laboratorium Badawczym to czekamy właśnie na Ciebie :)
Najważniejszymi obowiązkami na stanowisku Analityka (pierwsze stanowisko w karierze zawodowej na którym wszystkiego uczymy) będzie przygotowanie produktów do badań, dbanie o porządek na stanowisku pracy i realizacja zadań zleconych przez kierownika.
Rozpoczniesz pracę wśród specjalistów którzy zawsze chętnie doradzą Ci i pomogą w każdej sytuacji, a zakres obowiązków sprawi, że będziesz czuł realną możliwość rozwoju swoich kompetencji.
Wymagania:
- Brak jakiejkolwiek alergii pokarmowej, wybiórczości pokarmowej, palenia papierosów
- Doświadczenie w gastronomii
- Możliwość podjęcia współpracy 'od zaraz' na pełen etat
- Możliwość pracy stacjonarnej w naszej siedzibie głównej (Gdynia, Chwaszczyńska 180)
- Chęć współpracy długofalowej
- Umiejętność pracy w zespole
Mile widziane:
- Wykształcenie kierunkowe: towaroznastwo, gastronomia, technologia żywności
- Doświadczenie w gastronomii
Oferujemy:
- Zatrudnienie na podstawie umowy o pracę z wizją długofalowej współpracy
- Jasną ścieżkę rozwoju
- Pracę w dziale w którym osoba zarządzająca i zespół będą dbać i wspomagać twój rozwój
- Szkolenia zewnętrzne i wewnętrzne
- Pracę w kobiecym zespole
- Prywatną opiekę medyczną
- Polisę ubezpieczeniową
- Kartę MultiSport
- Pakiet relokacyjny
- Dostęp do największej darmowej platformy z możliwością samodzielnej nauki języka angielskiego
https://www.praca.pl/analityk-w-akredytowanym-laboratorium-badawczym-te…

